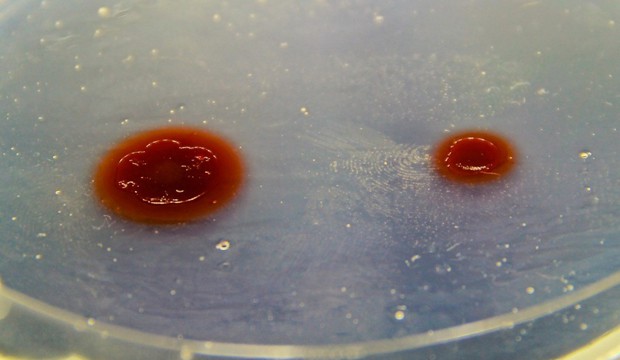
Bacteria that divide their metabolic labour (left colony) grow faster than bacterial cells that produce all amino acids on their own (right colony). Image by Samay Pande (MPI for Chemical Ecology).

The division of labour is more efficient than a struggle through life without help from others – this is also true for microorganisms. Researchers from Research Group Experimental Ecology and Evolution at the Max Planck Institute for Chemical Ecology and their colleagues at the Friedrich Schiller University in Jena, Germany came to this conclusion when they performed experiments with microbes. The scientists worked with bacteria that were deficient in the production of a certain amino acid and therefore depended on a partner to provide the missing nutrient. Bacterial strains that complemented each other’s need by providing the required amino acid showed a fitness increase of about 20% relative to a non-deficient strain without partner. This result helps to explain why cooperation is such a widespread model of success in nature.
Each life form on our planet has to adapt to its environment as good as it can. Apart from getting used to climate conditions and food supply, each species must get along with other organisms in the habitat. In the course of evolution species adapt continuously to each other and to the environment by changing their genetic features. This is why cold resistant species live at the poles and heat resistant species in the deserts. Also nutritional needs and metabolic regulation underlie the principle of evolution. So let’s take a look at the world of microbes in this context!
"No matter where you look: Microbial communities can be found in almost every habitat you can think of," says Christian Kost, leader of the research group “Experimental Ecology and Evolution” at the Max Planck Institute for Chemical Ecology in Jena, Germany. Microbes often live in symbiosis with higher organisms, but they also cooperate with each other in order to optimally utilize the resources that are available to them. Interestingly, a look at the genome of cooperating bacterial strains shows that some of them are unable to perform all vital metabolic functions on their own. Instead, they rely on their cooperative partner. Their environment, that is to say other organisms, provides the nutrients they cannot produce themselves anymore. However, the result of the cooperation is a risky dependency: If one partner is lost, the other dies as well. Can such a dependency in fact be a trait that is selected for and which is maintained for a longer period in a bacterial population? Is this assumption compatible with Darwin’s theory of the “survival of the fittest”? If so, cooperating partners should perform as good or even better than microbes without partner in terms of fitness.
To bring a naturally evolved symbiotic community from the real world into the lab to study such cooperation, is often very difficult. Therefore, scientists used a synthetic model: Escherichia coli bacteria were genetically modified in such a way that one bacterial strain was unable to produce a certain amino acid anymore, such as tryptophan, but produced all other amino acids in high concentrations. If this strain grows in a culture with another strain unable to produce arginine, another amino acid, both strains are able to feed each other. Amazingly, such co-culture experiments showed that the growth of these bacterial cells was increased by 20% in comparison to the unmodified wild-type strain that was able to produce all essential amino acid by itself. The inability of the deficient strain to produce an essential amino acid had a positive effect on its growth when a partner was present that compensated this loss. This can be explained by the considerably reduced energy costs both strains had to invest for producing the exchanged amino acids. Specializing on the production of certain, but not all necessary amino acids made the bacterial cells more efficient and thus resulted in faster growth. Interestingly, the two cooperating, amino acid exchanging strains even outcompeted a self-sustaining wild-type strain.
The research results from Christian Kost’s lab illustrate why symbiotic relationships with bacteria are so prevalent. In the course of evolution, an association may get so close that the mutualistic partners merge into a new, multicellular organism.
Cover image: Bacteria that divide their metabolic labour (left colony) grow faster than bacterial cells that produce all amino acids on their own (right colony). Image by Samay Pande (MPI for Chemical Ecology).
References
Pande, S., Merker, H., Bohl, K., Reichelt, M., Schuster, S., de Figueiredo, L., Kaleta, C., Kost, C. Fitness and stability of obligate cross-feeding interactions that emerge upon gene loss in bacteria. The ISME Journal. Advance online publication 28 November 2013. DOI: 10.1038/ismej.2013.211.
Stats
- Recommendations +1 100% positive of 1 vote(s)
- Views 6514
- Comments 0
Recommended
-

Alen Piljić
Managing director | Life Science Network gGmbH
Also:
- President | Research Elements Association